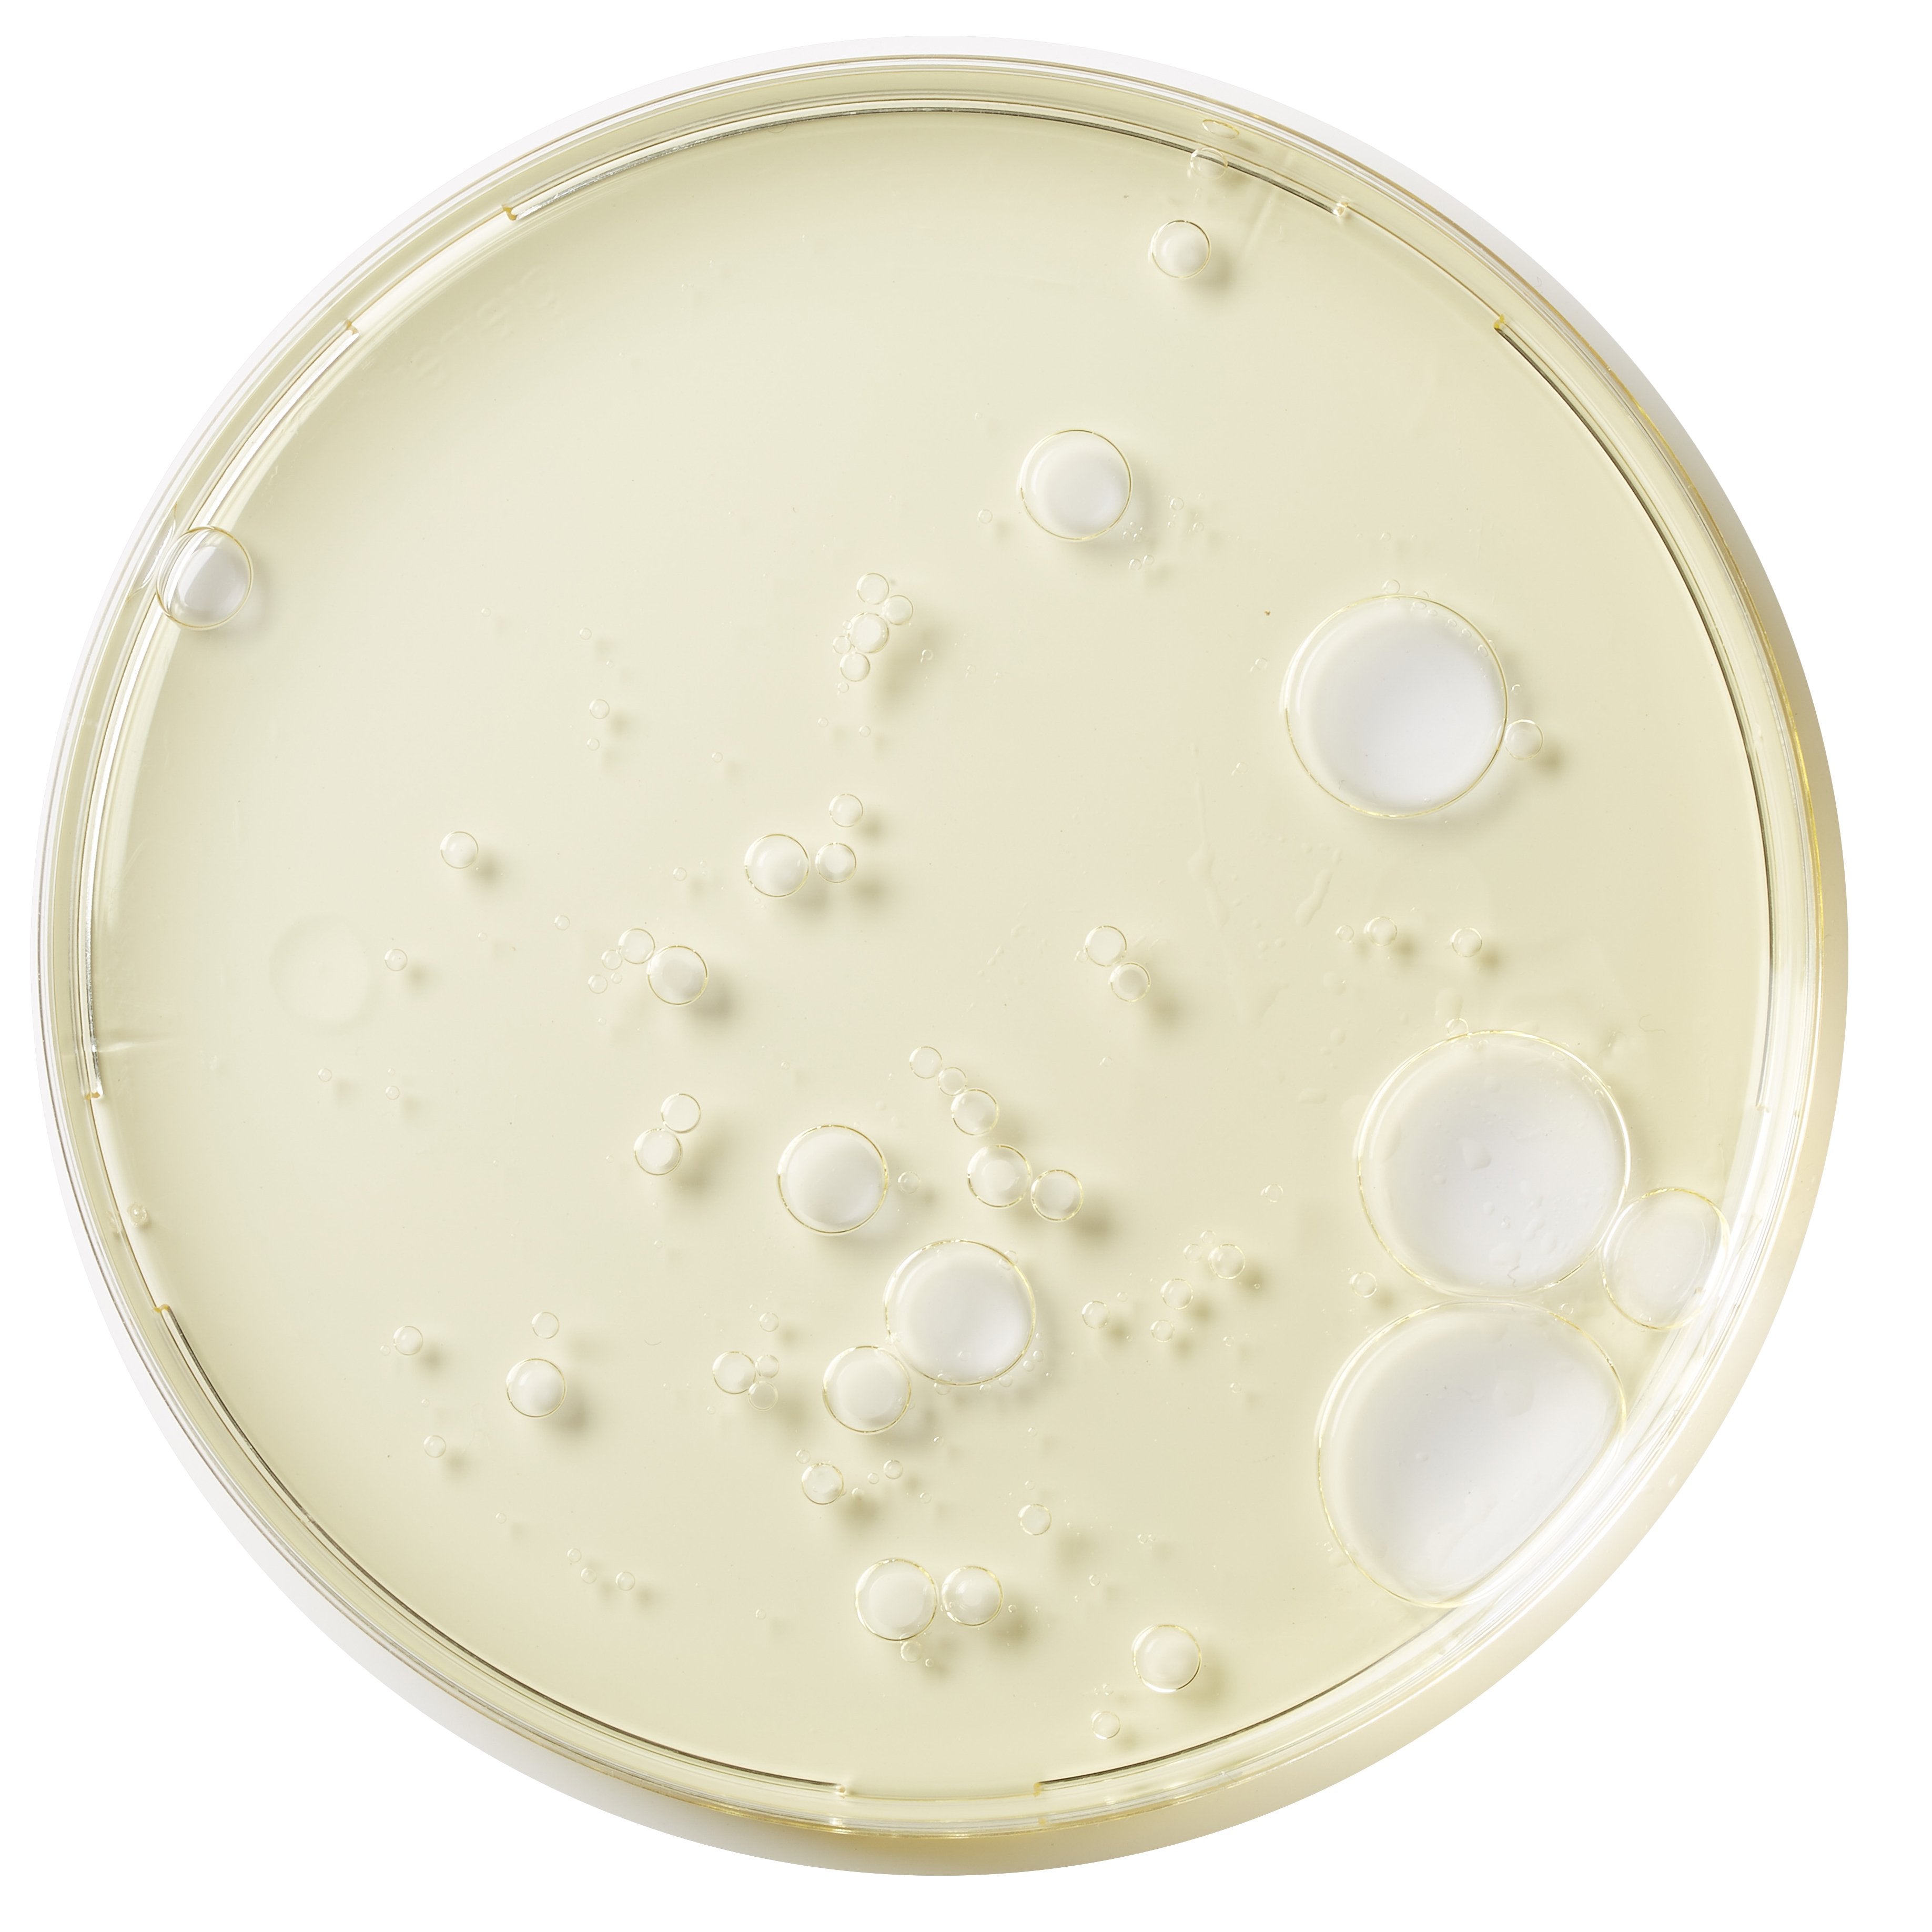
Kinvara Absolute Cleansing Oil (100ml)

1
/
of
11
Kinvara Absolute Cleansing Oil (100ml)
- Regular price
-
€26.95 - Regular price
-
- Sale price
-
€26.95
Tax included.
Couldn't load pickup availability
Kinvara Absolute Cleansing Oil is a hot cloth face cleanser made only from 100% plant oils that contains no harsh chemicals. It contains an innovative blend of skin loving plant oils to restore balance and cleanse your skin, gently and effectively.
-
Hurry, only 1 item left in stock!

Kinvara Absolute Cleansing Oil (100ml)
- Regular price
-
€26.95 - Regular price
-
- Sale price
-
€26.95
